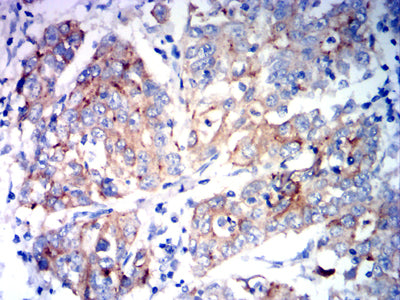

Mouse Monoclonal Antibody to KCNK1
货号:
32038
别名:
DPK; HOHO; K2P1; KCNO1; TWIK1; K2p1.1; TWIK-1
应用:
IHC,FCM
反应种属:
Human
抗体类型:
Primary antibody
Swissprot:
O00180
规格:
目录价
在线咨询
Description |
|---|
This gene encodes one of the members of the superfamily of potassium channel proteins containing two pore-forming P domains. The product of this gene has not been shown to be a functional channel, however, it may require other non-pore-forming proteins for activity. [provided by RefSeq, Jul 2008] |
References |
|---|
| 1,Biophys J. 2016 Aug 23;111(4):775-784. 2,J Biol Chem. 2020 Jan 10;295(2):610-618. |
Specification |
|
|---|---|
| Aliases | DPK; HOHO; K2P1; KCNO1; TWIK1; K2p1.1; TWIK-1 |
| Entrez GeneID | 3775 |
| Swissprot | O00180 |
| clone | 3C1B8 |
| WB Predicted band size | 38.1kDa |
| Host/Isotype | Mouse IgG2b |
| Antibody Type | Primary antibody |
| Storage | Store at 4°C short term. Aliquot and store at -20°C long term. Avoid freeze/thaw cycles. |
| Species Reactivity | Human |
| Immunogen | Purified recombinant fragment of human KCNK1 (AA: extra mix) expressed in E. Coli. |
| Formulation | Purified antibody in PBS with 0.05% sodium azide |
Application |
|
|---|---|
| IHC | 1/200 - 1/1000 |
| FCM | 1/200 - 1/400 |
| ELISA | 1/10000 |
Product Image
-
Black line: Control Antigen (100 ng);Purple line: Antigen (10ng); Blue line: Antigen (50 ng); Red line:Antigen (100 ng)

-
Flow cytometric analysis of C6 cells using KCNK1 mouse mAb (green) and negative control (red).

-
Flow cytometric analysis of HepG2 cells using KCNK1 mouse mAb (green) and negative control (red).

-
Immunohistochemical analysis of paraffin-embedded human esophageal cancer tissues using KCNK1 mouse mAb with DAB staining.

-
Immunohistochemical analysis of paraffin-embedded human stomach cancer tissues using KCNK1 mouse mAb with DAB staining.

鄂公网安备42018502007531号
鄂公网安备42018502007531号

